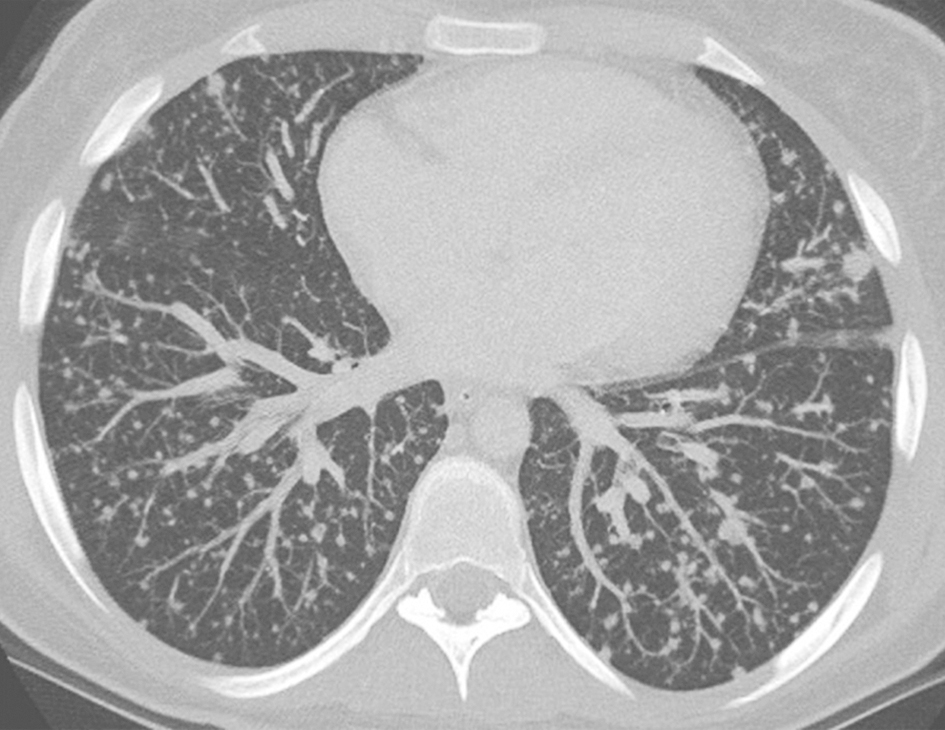
一例多灶微结节性肺泡上皮增生的诊治经验分享

-
一例混合型结缔组织病合并肺动脉高压诊治经验分享
环球医学资讯
2025年12月30日
点击量:23
1小时条评论33岁男性,因胸闷5天,发热4天,加重伴气促1天入院。患者胸闷、呼吸困难的原因是什么? 【病例简介】 患者男性,33岁,因胸闷5天,发热4天,加重伴气促1天于2018年2月2日入院。5天前因上呼吸道感染后出现心前区胸闷不适感,未予重视。4天前出现发热,高达40℃,伴...
-
一例肺泡蛋白沉积症的诊治经验分享
环球医学资讯
2025年12月25日
点击量:48
1小时条评论51岁男性,因咳嗽8个月,胸闷伴气促1个月入院。如何诊治? 一、入院疑诊 (一)病例信息 【病史】 男性患者,51岁,因咳嗽8个月,胸闷伴气促1个月入院。患者于8个月前,感冒后开始出现咳嗽,偶有咳痰,痰为黑色、量少,无畏寒、发热、胸痛、胸闷、咯...
-
一例典型的肺出血-肾炎综合征的诊治经验分享
环球医学资讯
2025年12月23日
点击量:32
1小时条评论23岁男性,肉眼血尿20天,咯血10天,如何诊治? 男性,23岁。 主诉 肉眼血尿20天,咯血10天。 现病史 20天前受凉后发热,体温38℃,伴咳嗽,咳少量白痰。2天后出现持续全程肉眼血尿,伴尿中泡沫增多。双下肢对称可凹性水肿,进行性加重,尿量不...
-
一例纯红细胞再生障碍性贫血并发肺栓塞病例解析
环球医学资讯
2025年12月21日
点击量:24
1小时条评论69岁女性,因胸闷、气促2天入院。该患者确诊纯红细胞再生障碍性贫血7年,定期输血治疗。患者此次突发胸闷、气促最可能的诊断是什么? 【病例简介】 患者女性,69岁,因胸闷、气促2天入院。患者2天前无明显诱因出现胸闷、气促,无头痛、胸痛,无视物模糊,无咳嗽、...
-
一例抗Jo-1抗体综合征合并干燥综合征伴间质性肺炎的…
环球医学资讯
2025年12月11日
点击量:39
1小时条评论女性患者,59岁,因咳嗽、咳痰伴活动后胸闷、气喘2个月入院。对于本病例,如何判断病因类别? 一、入院疑诊 (一)病例信息 【病史】 女性患者,59岁,因咳嗽、咳痰伴活动后胸闷、气喘2个月入院。患者自诉于2个月余前无明显诱因出现咳嗽、咳痰(白黏...
-
一例以胸腔积液为表现的肺结节病病例评析
环球医学资讯
2025年12月04日
点击量:33
1小时条评论52岁男性,慢性病程,以胸腔积液为主要表现。胸腔积液及病理未发现明显的肿瘤及感染证据。诊断性抗感染、抗结核和抗风湿治疗均无效。该患者所患何病? 【病例简介】 患者男性,52岁,银行职员。主因胸腔积液2年余,于2017年4月25日入院。患者2年前体检发现左侧胸腔...
-
一例多灶微结节性肺泡上皮增生的诊治经验分享
环球医学资讯
2025年11月21日
点击量:42
1小时条评论37岁男性患者,17个月前开始出现反复胸部隐痛,深吸气时明显,胸骨上段为主,无放射痛,与体位、运动无关,无发热、咳嗽、咳痰、咯血。肺部查体未见异常,后背散在皮疹。CT示两肺弥漫性粟粒样小结节影。抗结核治疗无效。本病例是感染性肺部疾病还是非感染性肺部疾病...
-
一例类风湿关节炎相关性间质性肺疾病病例解析
环球医学资讯
2025年11月16日
点击量:30
1小时条评论60岁男性,慢性起病,以咳嗽、咳痰伴气促为主要表现,起病时有发热,外院予抗感染治疗后体温正常,但肺部病灶无明显吸收。外院多次查肺CT及PET/CT提示右肺中叶斑片影,两肺下叶多发结节影、条索影、斑片影,局部支气管扩张。该患者有类风湿关节炎及糖尿病病史。其所...
-
一例巨细胞间质性肺炎的诊治经验分享
环球医学资讯
2025年11月13日
点击量:33
1小时条评论48岁男性患者,5个月前出现咳嗽,多为干咳,偶有少量白痰咳出,起初无明显气喘,间断至当地医院予青霉素等抗感染治疗,效果不佳。1个月前,患者自觉咳嗽症状加重,并出现活动后气喘,上二层楼即感气喘,于当地医院住院诊治,查胸部CT示双肺弥漫性病变。患者在机械厂...
-
一例家族性肺泡微结石症诊治经验分享
环球医学资讯
2025年10月24日
点击量:38
1小时条评论39岁女性,因发现肺部阴影26年,活动后胸闷、气短1个月余,加重伴咳嗽10天入院。如何诊治? 一、病例资料 女性,39岁,个体。患者因发现肺部阴影26年,活动后胸闷、气短1个月余,加重伴咳嗽10天于2015年6月9日入院。患者于1989年查体时,胸片示双肺阴影(具...

会员登录

